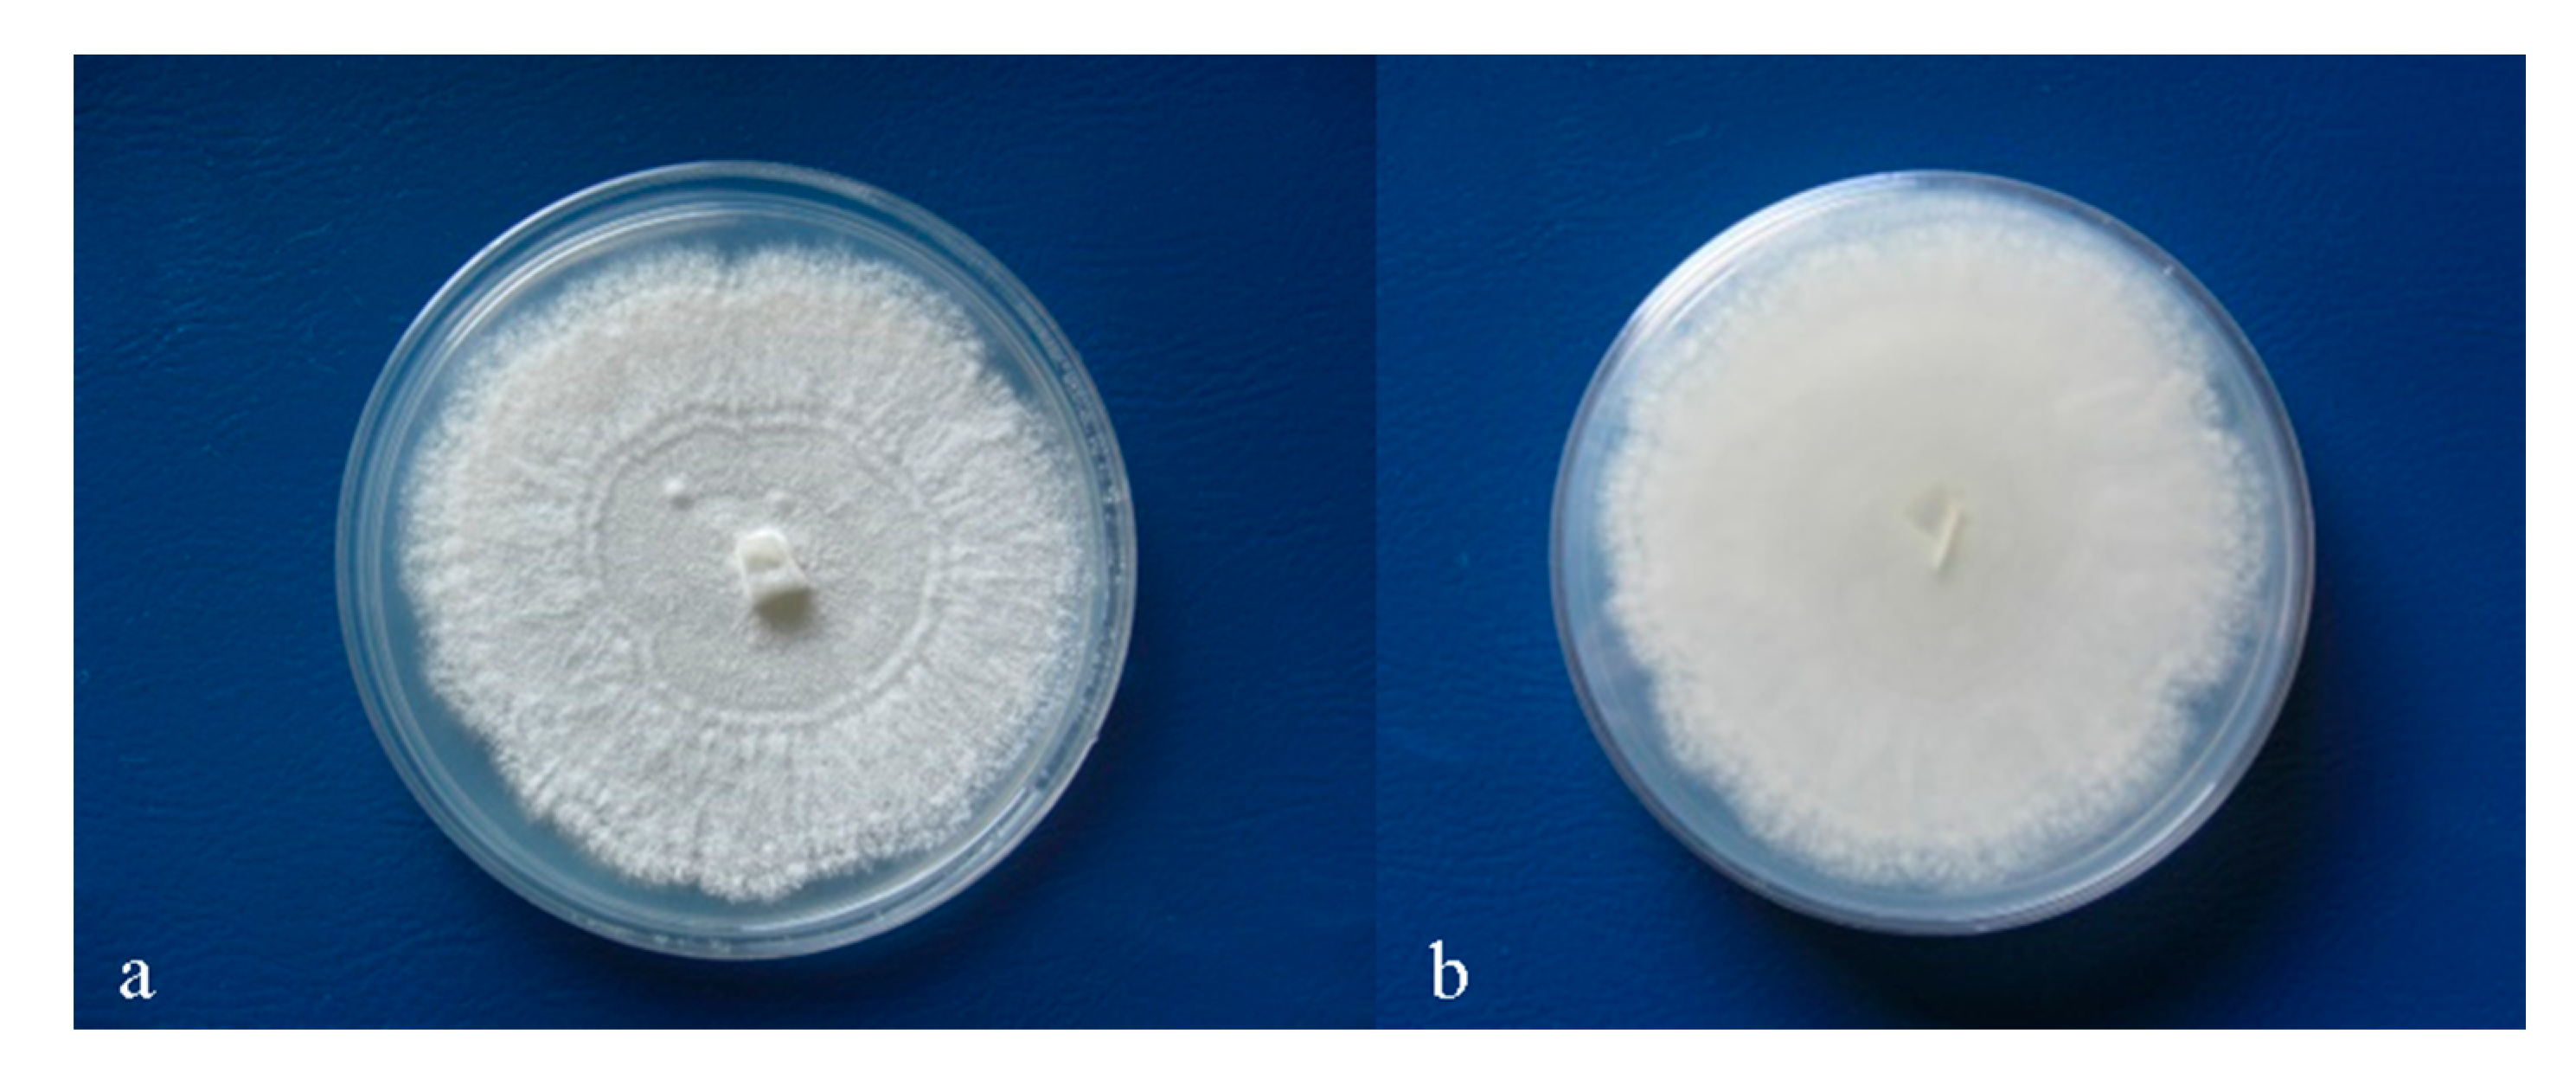

Selection of Elms Tolerant to Dutch Elm Disease in South-West Romania
Abstract
1. Introduction
2. Materials and Methods
2.1. Location and Experimental Trial Set up and Biological Material
2.2. Methods
2.2.1. Sampling
2.2.2. Fungal Isolation
2.2.3. Fungal Growth Rate and Colony Morphology
2.2.4. DNA Isolation, PCR, and Sequencing
2.2.5. RFLP Analysis of Cu and Col1 Gene
2.2.6. Virulence Test
2.2.7. Inventory
2.2.8. Selection of Individual Trees
2.2.9. Statistical Analysis
3. Results
3.1. Fungal Isolation from Different Elm Species
3.2. Colony Morphology and Fungal Growth Rate
3.3. DNA Isolation, PCR, and Sequencing of Pure Fungal Cultures of O. novo-ulmi
3.4. PCR-RFLP Analysis of Cu and Col1 Gene
3.5. Virulence Test
3.6. Health Status Recent Evolution
3.6.1. Ulmus minor
3.6.2. Ulmus glabra
3.6.3. Ulmus laevis
3.6.4. Differences among Elm Species
3.7. Selection of DED-Tolerant Plants
4. Discussion
5. Conclusions
Author Contributions
Funding
Institutional Review Board Statement
Data Availability Statement
Acknowledgments
Conflicts of Interest
References
- Kutnar, L.; Kermavnar, K.; Pintar, A.M. Climate change and disturbances will shape future temperate forests in the transition zone between Central and SE Europe. Ann. For. Res. 2021, 64, 67–86. [Google Scholar] [CrossRef]
- Anderson-Teixeira, K.J.; Herrmann, V.; Rollinson, C.R.; Gonzalez, B.; Gonzalez-Akre, E.B.; Pederson, N.; Zuidema, P.A. Joint effects of climate, tree size, and year on annual tree growth derived from tree-ring records of ten globally distributed forests. Glob. Chang. Biol. 2022, 28, 245. [Google Scholar] [CrossRef] [PubMed]
- Sajjad, H.; Kumar, P.; Masroor, M.; Rahaman, M.H.; Rehman, S.; Ahmed, R.; Sahana, M. Forest Vulnerability to Climate Change: A Review for Future Research Framework. Forests 2022, 13, 917. [Google Scholar] [CrossRef]
- Zhang, L.; Sun, P.; Huettmann, F.; Liu, S. Where should China practice forestry in a warming world? Glob. Chang. Biol. 2022, 28, 2461–2475. [Google Scholar] [CrossRef] [PubMed]
- Clark, K.L.; Skowronski, N.; Hom, J. Invasive insects impact forest carbon dynamics. Glob. Chang. Biol. 2010, 16, 88–101. [Google Scholar] [CrossRef]
- Santini, A.; Ghelardini, L.; De Pace, C.; Desprez-Loustau, M.L.; Capretti, P.; Chandelier, A.; Stenlid, J. Biogeographical patterns and determinants of invasion by forest pathogens in Europe. New Phytol. 2013, 197, 238–250. [Google Scholar] [CrossRef]
- Garnas, J.R.; Auger-Rozenberg, M.A.; Roques, A.; Bertelsmeier, C.; Wingfield, M.J.; Saccaggi, D.L.; Slippers, B. Complex patterns of global spread in invasive insects: Eco-evolutionary and management consequences. Biol. Invasions 2016, 18, 935–952. [Google Scholar] [CrossRef]
- Chira, D.; Bolea, V.; Chira, F.; Mantale, C.; Tăut, I.; Şimonca, V.; Diamandis, S. Biological control of Cryphonectria parasitica in Romanian protected sweet chestnut forests. Not. Bot. Horti Agrobot. 2017, 45, 632–638. [Google Scholar] [CrossRef]
- Seebens, H.; Bacher, S.; Blackburn, T.M.; Capinha, C.; Dawson, W.; Dullinger, S.; Essl, F. Projecting the continental accumulation of alien species through to 2050. Global Chang. Biol. 2021, 27, 970–982. [Google Scholar] [CrossRef]
- Anderson-Teixeira, K.J.; Herrmann, V.; Cass, W.B.; Williams, A.B.; Paull, S.J.; Gonzalez-Akre, E.B.; McShea, W.J. Long-Term Impacts of Invasive Insects and Pathogens on Composition, Biomass, and Diversity of Forests in Virginia’s Blue Ridge Mountains. Ecosystems 2021, 24, 89–105. [Google Scholar] [CrossRef]
- Schlarbaum, S.E.; Hebard, F.; Spaine, P.C.; Kamalay, J.C. Three American Tragedies: Chestnut Blight, Butternut Canker, and Dutch Elm Disease. In Exotic Pests of Eastern Forests Conference Proceedings; Britton, K.O., Ed.; US Forest Service and Tennessee Exotic Pest Plant Council: Nashville, TN, USA, 1998; pp. 45–54. [Google Scholar]
- Chira, D.; Dănescu, F.; Roşu, C.; Chira, F.; Mihalciuc, V.; Surdu, A.; Nicolescu, N.V. Some recent issues regarding the European beech decline in Romania. Ann. ICAS 2003, 46, 167–176. [Google Scholar]
- Fernández-Fernández, M.; Naves, P.; Musolin, D.L.; Selikhovkin, A.V.; Cleary, M.; Diez, J.J. Pine Pitch Canker and Insects: Regional Risks, Environmental Regulation, and Practical Management Options. Forests 2019, 10, 649. [Google Scholar] [CrossRef]
- Hyblerová, S.; Medo, J.; Barta, M. Diversity and prevalence of entomopathogenic fungi (Ascomycota, Hypocreales) in epidemic populations of bark beetles (Coleoptera, Scolytinae) in spruce forests of the Tatra National Park in Slovakia. Ann. For. Res. 2021, 64, 129–145. [Google Scholar] [CrossRef]
- Brasier, C.M.; Kirk, S.A.; Pipe, N.D.; Buck, K.W. Rare interspecific hybrids in natural populations of the Dutch elm disease pathogens Ophiostoma ulmi and O. novo-ulmi. Mycol. Res. 1998, 102, 45–57. [Google Scholar] [CrossRef]
- Brasier, C.M. Designation of the EAN and NAN races of Ophiostoma novo-ulmi as subspecies. Mycol. Res. 2001, 105, 547–554. [Google Scholar] [CrossRef]
- Solla, A.; Dacasa, M.C.; Nasmith, C.; Hubbes, M.; Gil, L. Analysis of Spanish populations of Ophiostoma ulmi and O. novo-ulmi using phenotypic characters and RAPD markers. Plant Pathol. 2008, 57, 33–44. [Google Scholar] [CrossRef]
- Hessenauer, P.; Fijarczyk, A.; Martin, H.; Prunier, J.; Charron, G.; Chapuis, J.; Landry, C.R. Hybridization and introgression drive genome evolution of Dutch elm disease pathogens. Nat. Ecol. Evol. 2020, 4, 626–638. [Google Scholar] [CrossRef]
- Konrad, H.; Kirisits, T.; Riegler, M.; Halmschlager, E.; Stauffer, C. Genetic evidence for natural hybridization between the Dutch elm disease pathogens Ophiostoma novo-ulmi ssp. novo-ulmi and O. novo-ulmi ssp. americana. Plant Pathol. 2002, 51, 78–84. [Google Scholar] [CrossRef]
- Brasier, C.M.; Mehrotra, M.D. Ophiostoma himal-ulmi sp. nov., a new species of Dutch elm disease fungus endemic to the Himalayas. Mycol. Res. 1995, 99, 205–215. [Google Scholar] [CrossRef]
- Mackenthun, G. Native Elms of Saxony, Germany. In The Elms: Breeding, Conservation, and Disease Management; Dunn, C., Ed.; Kluwer Academic Publisher: Boston, MA, USA, 2000; pp. 305–314. [Google Scholar]
- Hauer, R.J.; Hanou, I.S.; Sivyer, D. Planning for active management of future invasive pests affecting urban forests: The ecological and economic effects of varying Dutch elm disease management practices for street trees in Milwaukee, WI, USA. Urban Ecosyst. 2020, 23, 1005–1022. [Google Scholar] [CrossRef]
- Alexandri, A. Elm dieback in Romania. Bul. Sc. Stud. Şt. Naţ. Rom. 1933, III, 1–16. [Google Scholar]
- Brasier, C.M.; Kirk, S.A. Rapid emergence of hybrids between the two subspecies of Ophiostoma novo-ulmi with a high level of pathogenic fitness. Plant Pathol. 2010, 59, 186–199. [Google Scholar] [CrossRef]
- Petrescu, M.; Diţu, I.; Poleac, E.; Cucuianu, E. Dutch elm disease in Romania. St. Cerc. ICF 1967, XXIII B, 135–151. [Google Scholar]
- Borlea, G.F. Research on Breeding Resistance of Autochthonous elms to Ophiostoma novo-ulmi. Ph.D. Thesis, University Transilvania of Braşov, Brașov, Romania, 1996. [Google Scholar]
- Simionescu, A.; Mihalache, G. Forest Protection; Muşatinii: Suceava, Romania, 2000. [Google Scholar]
- Dinca, L. Field elm (Ulmus minor Mill.) stands the Moldavian plain. Land Reclam. Earth Obs. Surv. Environ. Eng. 2022, 11, 115–119. [Google Scholar]
- Simionescu, A.; Mihalciuc, V.; Lupu, D.; Vlăduleasa, A.; Badea, O.; Fulicea, T. Health Status of Romanian Forest in 1986–2000; Mușatinii: Suceava, Romania, 2001. [Google Scholar]
- Simionescu, A.; Chira, D.; Mihalciuc, V.; Ciornei, C.; Tulbure, C. Health Status of Romanian Forest in 2001–2010; Muşatinii Group: Suceava, Romania, 2012; 600p. [Google Scholar]
- Constandache, C.; Tudor, C.; Popovici, L.; Dincă, L. Ecological reconstruction of the stands affected by drought from meadows of inland rivers. Land Reclam. Earth Obs. Surv. Environ. Eng. 2022, 11, 76–84. [Google Scholar]
- Heybroek, H.M. The Dutch elm breeding program. In Dutch Elm Disease Research: Cellular and Molecular Approaches; Sticklen, M.B., Sherald, J., Eds.; Springer: New York, NY, USA, 1993; pp. 16–25. [Google Scholar]
- Smalley, E.B.; Guries, R.P. Breeding elms for resistance to Dutch elm disease. Annu. Rev. Phytopatol. 1993, 31, 325–354. [Google Scholar] [CrossRef]
- Solla, A.; Bohnens, J.; Collin, E.; Diamandis, S.; Franke, A.; Gil, L.; Broeck, A.V. Screening European elms for resistance to Ophiostoma novo-ulmi. For. Sci. 2005, 51, 134–141. [Google Scholar]
- Santini, A.; Pecori, F.; Ghelardini, L. The Italian elm breeding program for Dutch elm disease resistance. In Proceedings of the Fourth International Workshop on the Genetics of Host-Parasite Interactions in Forestry: Disease and Insect Resistance in Forest Trees, Eugene, OR, USA, 31 July–5 August 2011; Sniezko, R.A., Yanchuk, A.D., Kliejunas, J.T., Palmieri, K.M., Alexander, J.M., Frankel, S.J., Eds.; Gen. Tech. Rep. PSW-GTR-240. US Department of Agriculture: Albany, CA, USA, 2012; Volume 240, pp. 326–335. [Google Scholar]
- Collin, E.; Pozzi, T.; Joyeau, C.; Matz, S.; Rondouin, M.; Joly, C. Monitoring of the incidence of Dutch Elm Disease and mortality in experimental plantations of French Ulmus minor clones. iForest 2022, 15, 289. [Google Scholar] [CrossRef]
- Venturas, M.; López, R.; Martín, J.A.; Gascó, A.; Gil, L. Heritability of Ulmus minor resistance to Dutch elm disease and its relationship to vessel size, but not to xylem vulnerability to drought. Plant Pathol. 2014, 63, 500–509. [Google Scholar] [CrossRef]
- Martín, J.A.; Domínguez, J.; Solla, A.; Brasier, C.M.; Webber, J.F.; Santini, A.; Gil, L. Complexities underlying the breeding and deployment of Dutch elm disease resistant elms. New For. 2021, 1–36. [Google Scholar] [CrossRef]
- Moravčík, M.; Mamoňová, M.; Račko, V.; Kováč, J.; Dvořák, M.; Krajňáková, J.; Ďurkovič, J. Different Responses in Vascular Traits between Dutch Elm Hybrids with a Contrasting Tolerance to Dutch Elm Disease. J. Fungi 2022, 8, 215. [Google Scholar] [CrossRef] [PubMed]
- Islam, M.T.; Coutin, J.F.; Shukla, M.; Dhaliwal, A.K.; Nigg, M.; Bernier, L.; Saxena, P.K. Deciphering the Genome-Wide Transcriptomic Changes during Interactions of Resistant and Susceptible Genotypes of American Elm with Ophiostoma novo-ulmi. J. Fungi 2022, 8, 120. [Google Scholar] [CrossRef] [PubMed]
- Martín, J.A.; Sobrino-Plata, J.; Rodríguez-Calcerrada, J.; Collada, C.; Gil, L. Breeding and scientific advances in the fight against Dutch elm disease: Will they allow the use of elms in forest restoration? New For. 2019, 50, 183–215. [Google Scholar] [CrossRef]
- Brasier, C.M.; Webber, J.F. Is there evidence for post-epidemic attenuation in the Dutch elm disease pathogen Ophiostoma novo-ulmi? Plant Pathol. 2019, 68, 921–929. [Google Scholar] [CrossRef]
- Giurgiu, V. Saving of natural forests. In Protection and Sustainable Development of Romanian Forests; Giurgiu, V., Ed.; Arta Grafică: București, Romania, 1995; pp. 104–109. [Google Scholar]
- Borlea, G.F. Ecology of elms in Romania. For. Syst. 2004, 13, 29–35. [Google Scholar]
- Copernicus Europe’s Eye on Earth. Land Monitoring Service. Available online: https://land.copernicus.eu/pan-european/corine-land-cover/clc2018 (accessed on 7 November 2022).
- Mang, S.M.; Racioppi, R.; Camele, I.; Rana, G.L. Use of volatile metabolite profile to distinguish three Monilia species. J. Plant Pathol. 2015, 97, 55–59. [Google Scholar] [CrossRef]
- Brasier, C.M. Laboratory investigation of Ceratocystis ulmi. In Compendium of Elm Diseases; Stipes, R.J., Campana, R.J., Eds.; American Phytopathological Society: St Paul, MN, USA, 1981; pp. 76–79. [Google Scholar]
- Mang, S.M.; Figluolo, G. Species delimitation in Pleurotus eryngii species-complex inferred from ITS and EF1-α gene sequences. Mycology 2010, 1, 269–280. [Google Scholar] [CrossRef]
- White, T.J.; Bruns, T.; Lee, S.; Taylor, J. Amplified and direct sequencing of fungal ribosomal RNA genes for phylogenetics. In PCR Protocols: A Guide to Methods and Applications; Innis, M.A., Gelfand, D.H., Sninsky, J.J., White, T.J., Eds.; Academic: San Diego, CA, USA, 1990; pp. 315–322. [Google Scholar]
- Glass, N.L.; Donaldson, G.C. Development of primer sets designed for use with the PCR to amplify conserved genes from filamentous ascomycetes. Appl. Environ. Microbiol. 1995, 61, 1323–1330. [Google Scholar] [CrossRef]
- Pipe, N.D.; Buck, K.W.; Brasier, C.M. Comparison of the cerato-ulmin (cu) gene sequences of the Himalayan Dutch elm disease fungus Ophiostoma himal-ulmi with those of O. ulmi and O. novo-ulmi suggests that the cu gene of O. novo-ulmi is unlikely to have been acquired recently from O. himal-ulmi. Mycol. Res. 1997, 101, 415–421. [Google Scholar] [CrossRef]
- Mentana, A.; Camele, I.; Mang, S.M.; De Benedetto, G.E.; Frisullo, S.; Centonze, D. Volatolomics approach by HS-SPME-GC-MS and multivariate analysis to discriminate olive tree varieties infected by Xylella fastidiosa. Phytochem. Anal. 2019, 30, 623–634. [Google Scholar] [CrossRef]
- Frisullo, S.; Elshafie, H.S.; Mang, S.M. First report of two Phomopsis species on olive trees in Italy. J. Plant Pathol. 2015, 97, 401. [Google Scholar] [CrossRef]
- Altschul, S.F.; Gish, W.; Miller, W.; Myers, E.W.; Lipman, J.D. Basic Local Alignment Search Tool. J. Mol. Biol. 1990, 215, 403–410. [Google Scholar] [CrossRef]
- Johnson, M.; Zaretskaya, I.; Raytselis, Y.; Merezhuk, Y.; Mcginnis, S.; Madden, T.L. NCBI BLAST: A better web interface. Nucleic Acids Res. 2008, 36 (Suppl. 2), W5–W9. [Google Scholar] [CrossRef] [PubMed]
- Plourde, K.V.; Bernier, L. A rapid virulence assay for the Dutch elm disease fungus Ophiostoma novo-ulmi by inoculation of apple (Malus × domestica ‘Golden Delicious’) fruits. Plant Pathol. 2014, 63, 1078–1085. [Google Scholar] [CrossRef]
- ICP Forests. Visual Assessment of Crown Condition and Damaging Agents. 2021. Available online: http://icp-forests.net/page/icp-forests-manual (accessed on 25 July 2021).
- Burnham, K.P.; Anderson, D.R. Multimodel Inference: Understanding AIC and BIC in Model Selection. Sociol Methods Res. 2004, 33, 261–304. [Google Scholar] [CrossRef]
- R Core Team. R: A Language and Environment for Statistical Computing; R Foundation for Statistical Computing: Vienna, Austria, 2021; Available online: https://www.R-project.org (accessed on 15 December 2021).
- Bates, D.; Mächler, M.; Bolker, B.M.; Walker, S.C. Fitting linear mixed-effects models using lme4. J. Stat. Softw. 2015, 67. [Google Scholar] [CrossRef]
- Kuznetsova, A.; Brockhoff, P.B.; Christensen, R.H.B. lmerTest Package: Tests in Linear Mixed Effects Models. J. Stat. Softw. 2017, 82, 1–26. [Google Scholar] [CrossRef]
- Brasier, C.; Franceschini, S.; Forster, J.; Kirk, S. Enhanced outcrossing, directional selection and transgressive segregation drive evolution of novel phenotypes in hybrid swarms of the Dutch elm disease pathogen Ophiostoma novo-ulmi. J. Fungi 2021, 7, 452. [Google Scholar] [CrossRef]
- Brasier, C.M.; Bates, M.R.; Charter, N.W.; Buck, K.W. DNA Polymorphism, Perithecial Size and Molecular Aspects of D Factors in Ophiostoma-ulmi and O. novo-ulmi. In Dutch Elm Disease Research; Springer: New York, NY, USA, 1993; pp. 308–321. [Google Scholar]
- Katanić, Z.; Krstin, L.; Ježić, M.; Ćaleta, B.; Stančin, P.; Zebec, M.; Ćurković-Perica, M. Identification and characterization of the causal agent of Dutch elm disease in Croatia. Eur. J. For. Res. 2020, 139, 805–815. [Google Scholar] [CrossRef]
- Santini, A.; Montaghi, A.; Vendramin, G.G.; Capretti, P. Analysis of the Italian Dutch elm disease population. J. Phytopathol. 2005, 153, 73–79. [Google Scholar] [CrossRef]
- Dvořák, M.; Tomšovský, M.; Jankovský, L.; Novotný, D. Contribution to identify the causal agents of Dutch elm disease in the Czech Republic. Plant Prot. Sci. 2007, 43, 142–145. [Google Scholar] [CrossRef]
- Townsend, A.M. Relative resistance of diploid Ulmus species to Ceratocystis ulmi. Plant Dis. Rep. 1971, 55, 980–982. [Google Scholar]
- Brasier, C.M. Inheritance of pathogenicity and cultural characters in Ceratocystis ulmi; hybridization of protoperithecial and non-aggressive strains. Trans. Br. Mycol. Soc. 1977, 68, 45–52. [Google Scholar] [CrossRef]
- Jürisoo, L.; Selikhovkin, A.V.; Padari, A.; Shevchenko, S.V.; Shcherbakova, L.N.; Popovichev, B.G.; Drenkhan, R. The extensive damage to elms by Dutch elm disease agents and their hybrids in northwestern Russia. Urban For. Urban Green. 2021, 63, 127214. [Google Scholar] [CrossRef]
- Sacchetti, P.; Tiberi, R.; Mittempergher, L. Preference of Scolytus multistriatus (Marsham) during the gonad maturation phase between two species of elm. Redia 1990, 73, 347–354. [Google Scholar]
- Webber, J. Insect vector behaviour and the evolution of Dutch elm disease. In The Elms: Breeding, Conservation and Disease Management; Dunn, C.P., Ed.; Kluwer: Boston, MA, USA, 2000; pp. 47–60. [Google Scholar]
- Pajares, J.A.; García, S.; Díez, J.J.; Martín, D.; García-Vallejo, M.C. Feeding responses by Scolytus scolytus to twig bark extracts from elms. For. Syst. 2004, 13, 217–225. [Google Scholar]
- Dvořák, M.; Palovčíková, D.; Jankovský, L. The occurrence of endophytic fungus Phomopsis oblonga on elms in the area of southern Bohemia. J. For. Sci. 2012, 52, 531–535. [Google Scholar] [CrossRef]
- Macaya-Sanz, D.; Witzell, J.; Collada, C.; Gil, L.; Martín, J.A. Structure of core fungal endobiome in Ulmus minor: Patterns within the tree and across genotypes differing in tolerance to Dutch elm disease. bioRxiv 2020. [Google Scholar] [CrossRef]
- Martínez-Arias, C.; Sobrino-Plata, J.; Ormeño-Moncalvillo, S.; Gil, L.; Rodríguez-Calcerrada, J.; Martín, J.A. Endophyte inoculation enhances Ulmus minor resistance to Dutch elm disease. Fungal Ecol. 2021, 50, 101024. [Google Scholar] [CrossRef]
- Anderbrant, O.; Yuvaraj, J.K.; Martin, J.A.; Gil, J.L.; Witzell, J. Feeding by Scolytus bark beetles to test for differently susceptible elm varieties. J. Appl. Entomol. 2017, 141, 417–420. [Google Scholar] [CrossRef]
- Collin, E.; Bozzano, M. Implementing the dynamic conservation of elm genetic resources in Europe: Case studies and perspectives. iForest 2015, 8, 143–148. [Google Scholar] [CrossRef]
- Domínguez, J.; Macaya-Sanz, D.; Gil, L.; Martín, J.A. Excelling the progenitors: Breeding for resistance to Dutch elm disease from moderately resistant and susceptible native stock. For. Ecol. Manag. 2022, 511, 120113. [Google Scholar] [CrossRef]
- Smucker, S.J. Comparison of susceptibility of American elm and several exotic elms to Ceratostomella ulmi. Phytopathology 1941, 31, 758–759. [Google Scholar]
- Webber, J.F. Experimental studies on factors influencing the transmission of Dutch elm disease. For. Syst. 2004, 13, 197–205. [Google Scholar]
- Mittempergher, L.; La Porta, N. Ophiostoma ulmi/Olmo. In Miglioramento Genetico Delle Piante per Resistenza a Patogeni e Parassiti; Crino, P., Ed.; Edagricole: Bologne, Italy, 1993; pp. 412–432. [Google Scholar]
- Collin, E. Strategies and guidelines for the conservation of the genetic resources of Ulmus spp. In Noble Hardwoods Network; International Plant Genetic Resources Institute: Rome, Italy, 2002; pp. 50–67. [Google Scholar]
- Torre, S.; Sebastiani, F.; Burbui, G.; Pecori, F.; Pepori, A.L.; Passeri, I.; Santini, A. Novel Insights into Refugia at the Southern Margin of the Distribution Range of the Endangered Species Ulmus laevis. Front. Plant Sci. 2022, 13, 826158. [Google Scholar] [CrossRef]
- Kännaste, A.; Jürisoo, L.; Runno-Paurson, E.; Talts, E.; Drenkhan, R.; Niinemets, Ü. Impacts of Dutch elm disease-causing fungi on foliage photosynthetic characteristics and volatiles in Ulmus species with different pathogen resistance. Tree Physiol. 2022. accepted for publication. [Google Scholar] [CrossRef]
- Climate Timișoara (Romania). 2021. Available online: https://en.climate-data.org/europe/romania/timis/timisoara-997/ (accessed on 12 August 2022).
- Rigling, D.; Prospero, S. Cryphonectria parasitica, the causal agent of chestnut blight: Invasion history, population biology and disease control. Mol. Plant Pathol. 2018, 19, 7–20. [Google Scholar] [CrossRef]
- Landolt, J.; Gross, A.; Holdenrieder, O.; Pautasso, M. Ash dieback due to Hymenoscyphus fraxineus: What can be learnt from evolutionary ecology? Plant Pathol. 2016, 65, 1056–1070. [Google Scholar] [CrossRef]
- Chira, D.; Chira, F.; Tăut, I.; Popovici, O.; Blada, I.; Doniţă, N.V.; Dinu, C. Evolution of ash dieback in Romania. In Dieback of European Ash (Fraxinus spp.)-Consequences and Guidelines for Sustainable Management; Vasaitis, R., Enderle, R., Eds.; Swedish University of Agricultural Sciences: Uppsala, Sweden, 2017; pp. 185–194. [Google Scholar]
- Griffiths, S.M.; Galambao, M.; Rowntree, J.; Goodhead, I.; Hall, J.; O’Brien, D.; Antwis, R.E. Complex associations between cross-kingdom microbial endophytes and host genotype in ash dieback disease dynamics. J. Ecol. 2020, 108, 291–309. [Google Scholar] [CrossRef]
- Buiteveld, J.; Van Der Werf, B.; Hiemstra, J.A. Comparison of commercial elm cultivars and promising unreleased Dutch clones for resistance to Ophiostoma novo-ulmi. iForest 2015, 8, 158. [Google Scholar] [CrossRef]
- Townsend, A.M.; Bentz, S.E.; Douglass, L.W. Evaluation of 19 American elm clones for tolerance to Dutch elm disease. J. Environ. Hortic. 2005, 23, 21–24. [Google Scholar] [CrossRef]
- Collin, E.; Rondouin, M.; Joyeau, C.; Matz, S.; Raimbault, P.; Harvengt, L.; Bilger, I.; Guibert, M. Conservation and use of elm genetic resources in France: Results and perspectives. iForest 2020, 13, 41–47. [Google Scholar] [CrossRef]
- Budeanu, M.; Apostol, E.N.; Radu, R.G.; Ioniță, L. Genetic variability and juvenile–adult correlations of Norway spruce (Picea abies) provenances, tested in multisite comparative trials. Ann. For. Res. 2021, 64, 105–122. [Google Scholar] [CrossRef]
- Ducci, F.; De Rogatis, A.; Proietti, R.; Curtu, A.L.; Marchi, M.; Belletti, P. Establishing a baseline to monitor future climate-change-effects on peripheral populations of Abies alba in central Apennines. Ann. For. Res. 2021, 64, 33–66. [Google Scholar] [CrossRef]
- Mihai, G.; Alexandru, A.M.; Nita, I.A.; Birsan, M.V. Climate Change in the Provenance Regions of Romania over the Last 70 Years: Implications for Forest Management. Forests 2022, 13, 1203. [Google Scholar] [CrossRef]
- Prăvălie, R.; Sîrodoev, I.; Nita, I.A.; Patriche, C.; Dumitraşcu, M.; Roşca, B.; Birsan, M.V. NDVI-based ecological dynamics of forest vegetation and its relationship to climate change in Romania during 1987–2018. Ecol. Indic. 2022, 136, 108629. [Google Scholar] [CrossRef]

| Locus * | Primer Name | Primer Sequence | Reference |
|---|---|---|---|
| ITS | ITS5 | 5′-GGAAGTAAAAGTCGTAACAAGG-3′ | [49] |
| ITS4 | 5′-TCCTCCGCTTATTGATATGC-3′ | ||
| TUB-2 | Bt2a | 5′-GGTAACCAAATCGGTGCTGCTTTC-3′ | [50] |
| Bt2b | 5′-ACCCTCAGTGTAGTGACCCTTGGC-3′ | ||
| Cu | CU1-Fwd | 5-GGGCAGCTTACCAGAGTGAAC-3′ | [51] |
| CU2-Rev | 5-GCGTTATGATGTAGCGGTGGC-3′ | ||
| col1 | Col1-F | 5-GCAGTTGTTGACATGTA G-3′ | [19] |
| Col1-R | 5-TGCTTGACGTAGATCTCG-3′ |
| Genes/GenBank Accession Number | |||||
|---|---|---|---|---|---|
| Isolate Name | Host | ITS | TUB-2 | Cu | Col1 |
| Oph_TM1 | Ulmus glabra | OP748295 | OP817142 | OP787366 | OP794345 |
| Oph_TM2 | Ulmus glabra | OP748296 | OP817143 | OP787367 | OP794346 |
| Oph_TM3 | Ulmus glabra | OP748297 | OP817144 | OP787368 | OP794347 |
| Oph_TM4 | Ulmus glabra | OP748298 | OP817145 | OP787369 | OP794348 |
| Oph_TM5 | Ulmus minor | OP748299 | OP817146 | OP787370 | OP794349 |
| Oph_TM6 | Ulmus minor | OP748300 | OP817147 | OP787371 | OP794350 |
| Oph_TM7 | Ulmus minor | OP748301 | OP817148 | OP787372 | OP794351 |
| Oph_TM8 | Ulmus minor | OP748302 | OP817149 | OP787373 | OP794352 |
| Oph_TM9 | Ulmus minor | OP748303 | OP817150 | OP787374 | OP794353 |
| Oph_TM10 | Ulmus laevis | OP748304 | OP817151 | OP787375 | OP794354 |
| Oph_TM11 | Ulmus laevis | OP748305 | OP817152 | OP787376 | OP794355 |
| Oph_TM12 | Ulmus laevis | OP748306 | OP817153 | OP787377 | OP794356 |
| Isolate Name | Digestion Enzyme | Size (bp) and Presence/Absence * of the Bands after Digestion | |||||
|---|---|---|---|---|---|---|---|
| 100 | 101 | 156 | 161 | 236 | 632 | ||
| Oph_TM1 | HphI | - | + | - | + | - | + |
| Oph_TM2 | HphI | - | + | - | + | - | + |
| Oph_TM3 | HphI | - | + | - | + | - | + |
| Oph_TM4 | HphI | - | + | - | + | - | + |
| Oph_TM5 | HphI | - | + | - | + | - | + |
| Oph_TM6 | HphI | - | + | - | + | - | + |
| Oph_TM7 | HphI | - | + | - | + | - | + |
| Oph_TM8 | HphI | - | + | - | + | - | + |
| Oph_TM9 | HphI | - | + | - | + | - | + |
| Oph_TM10 | HphI | - | + | - | + | - | + |
| Oph_TM11 | HphI | - | + | - | + | - | + |
| Oph_TM12 | HphI | - | + | - | + | - | + |
| Oph_TM1 | FspBI | + | - | + | - | + | - |
| Oph_TM2 | FspBI | + | - | + | - | + | - |
| Oph_TM3 | FspBI | + | - | + | - | + | - |
| Oph_TM4 | FspBI | + | - | + | - | + | - |
| Oph_TM5 | FspBI | + | - | + | - | + | - |
| Oph_TM6 | FspBI | + | - | + | - | + | - |
| Oph_TM7 | FspBI | + | - | + | - | + | - |
| Oph_TM8 | FspBI | + | - | + | - | + | - |
| Oph_TM9 | FspBI | + | - | + | - | + | - |
| Oph_TM10 | FspBI | + | - | + | - | + | - |
| Oph_TM11 | FspBI | + | - | + | - | + | - |
| Oph_TM12 | FspBI | + | - | + | - | + | - |
| Provenance | No | Def | D | ||||
|---|---|---|---|---|---|---|---|
| 2018 | 2019 | 2020 | 2021 | 2019 | 2021 | ||
| 13 (Gurahont) | 48 | 57.3 | 59.9 | 66.8 | 71.9 | 13.1 | 14.0 |
| 14 (Băneasa 1) | 46 | 41.7 | 46.8 | 51.1 | 53.9 | 12.4 | 13.9 |
| 15 (Timișoara 1) | 13 | 38.1 | 42.3 | 45.0 | 47.7 | 12.0 | 13.5 |
| 29 (Timișoara2) | 37 | 58.9 | 59.3 | 63.1 | 62.4 | 12.2 | 13.5 |
| 30 (Băneasa 2) | 27 | 54.1 | 61.1 | 62.8 | 64.8 | 14.1 | 15.4 |
| Average | 51.5 | 55.1 | 59.5 | 62.1 | 12.8 | 14.0 |
| Provenance | No | Def | D | ||||
|---|---|---|---|---|---|---|---|
| 2018 | 2019 | 2020 | 2021 | 2019 | 2021 | ||
| 1 (Retezat CA1) | 15 | 60.3 | 68.0 | 70.0 | 74.0 | 9.3 | 9.7 |
| 2 (Retezat CA2) | 15 | 60.7 | 66.3 | 74.3 | 77.7 | 7.9 | 8.5 |
| 3 (Gurahonț) | 18 | 81.4 | 91.1 | 94.2 | 94.7 | 6.5 | 6.58 |
| 4 (Văliug) | 5 | 96.0 | 96.0 | 100 | 100 | 8.5 | 8.5 |
| 5 (Bozovici) | 5 | 75.0 | 86.0 | 96.0 | 100 | 5.6 | 5.6 |
| 6 (Anina) | 7 | 85.7 | 85.7 | 86.4 | 86.4 | 7.7 | 8.0 |
| 7 (Retezat Rotunda) | 1 | 100 | 100 | 100 | 100 | 15.2 | 15.2 |
| 8 (Herculane) | 3 | 100 | 100 | 100 | 100 | 17.0 | 17.0 |
| Average | 74.4 | 80.7 | 84.9 | 86.7 | 8.2 | 8.5 |
| Provenience | No | Def | D | ||||
|---|---|---|---|---|---|---|---|
| 2018 | 2019 | 2020 | 2021 | 2019 | 2021 | ||
| 35 (Timișoara) | 41 | 18.8 | 22.6 | 25.6 | 27.7 | 10.3 | 12.2 |
| 36 (Pecica-Ceala) | 41 | 16.7 | 19.3 | 28.4 | 36.6 | 8.4 | 10.5 |
| Average | 17.7 | 20.9 | 27.0 | 32.1 | 9.2 | 11.2 |
Publisher’s Note: MDPI stays neutral with regard to jurisdictional claims in published maps and institutional affiliations. |
© 2022 by the authors. Licensee MDPI, Basel, Switzerland. This article is an open access article distributed under the terms and conditions of the Creative Commons Attribution (CC BY) license (https://creativecommons.org/licenses/by/4.0/).
Share and Cite
Chira, D.; Borlea, F.G.; Chira, F.; Mantale, C.Ș.; Ciocîrlan, M.I.C.; Turcu, D.O.; Cadar, N.; Trotta, V.; Camele, I.; Marcone, C.; et al. Selection of Elms Tolerant to Dutch Elm Disease in South-West Romania. Diversity 2022, 14, 980. https://doi.org/10.3390/d14110980
Chira D, Borlea FG, Chira F, Mantale CȘ, Ciocîrlan MIC, Turcu DO, Cadar N, Trotta V, Camele I, Marcone C, et al. Selection of Elms Tolerant to Dutch Elm Disease in South-West Romania. Diversity. 2022; 14(11):980. https://doi.org/10.3390/d14110980
Chicago/Turabian StyleChira, Dănuț, Florian G. Borlea, Florentina Chira, Costel Ș. Mantale, Mihnea I. C. Ciocîrlan, Daniel O. Turcu, Nicolae Cadar, Vincenzo Trotta, Ippolito Camele, Carmine Marcone, and et al. 2022. "Selection of Elms Tolerant to Dutch Elm Disease in South-West Romania" Diversity 14, no. 11: 980. https://doi.org/10.3390/d14110980
APA StyleChira, D., Borlea, F. G., Chira, F., Mantale, C. Ș., Ciocîrlan, M. I. C., Turcu, D. O., Cadar, N., Trotta, V., Camele, I., Marcone, C., & Mang, Ș. M. (2022). Selection of Elms Tolerant to Dutch Elm Disease in South-West Romania. Diversity, 14(11), 980. https://doi.org/10.3390/d14110980

